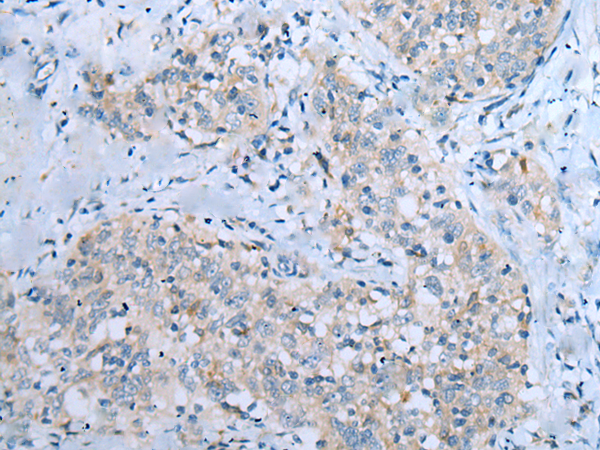

中文名稱(chēng):兔抗CD209多克隆抗體
英文名稱(chēng): Anti-CD209 rabbit polyclonal antibody
別 名: CDSIGN; CLEC4L; DC-SIGN; DC-SIGN1
相關(guān)類(lèi)別: 一抗
儲(chǔ) 存: 冷凍(-20℃)
宿 主: Rabbit
抗 原: CD209
反應(yīng)種屬: Human
標(biāo) 記 物: Unconjugate
克隆類(lèi)型: rabbit polyclonal
技術(shù)規(guī)格
|
Background: |
This gene encodes a transmembrane receptor and is often referred to as DC-SIGN because of its expression on the surface of dendritic cells and macrophages. The encoded protein is involved in the innate immune system and recognizes numerous evolutionarily divergent pathogens ranging from parasites to viruses with a large impact on public health. The protein is organized into three distinct domains: an N-terminal transmembrane domain, a tandem-repeat neck domain and C-type lectin carbohydrate recognition domain. |
|
Applications: |
ELISA, WB, IHC |
|
Name of antibody: |
CD209 |
|
Immunogen: |
Synthetic peptide of human CD209 |
|
Full name: |
CD209 molecule |
|
Synonyms: |
CDSIGN; CLEC4L; DC-SIGN; DC-SIGN1 |
|
SwissProt: |
Q9NNX6 |
|
ELISA Recommended dilution: |
5000-10000 |
|
IHC positive control: |
Human esophagus cancer and human liver cancer |
|
IHC Recommend dilution: |
10-50 |
|
WB Predicted band size: |
46 kDa |
|
WB Positive control: |
Hela cell |
|
WB Recommended dilution: |
200-1000 |

購(gòu)物車(chē)
幫助
021-54845833/15800441009
